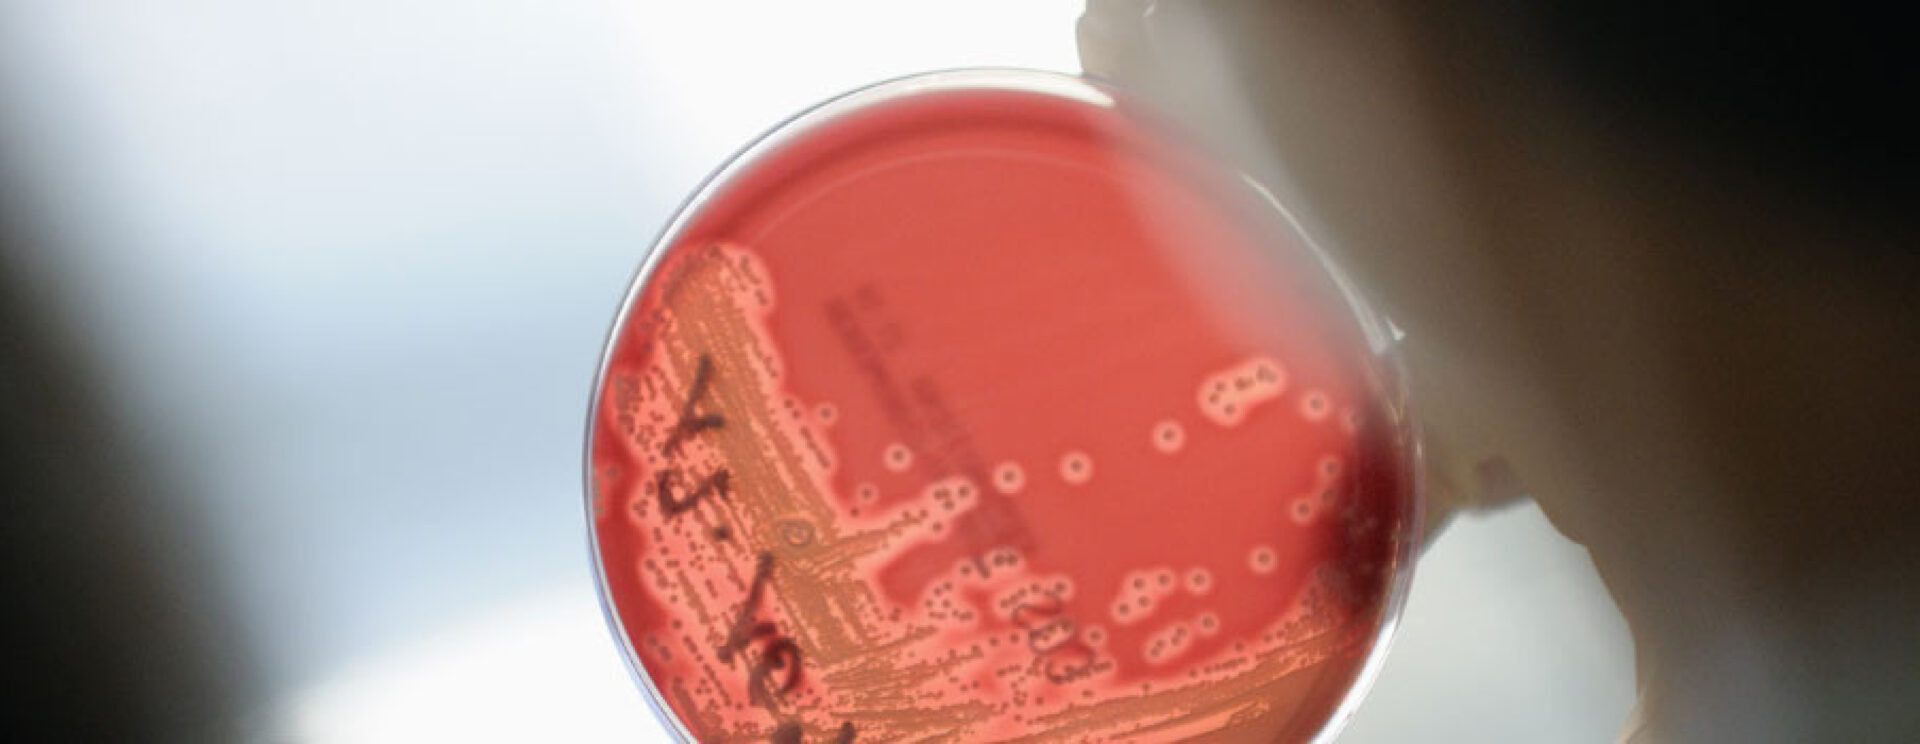

Laboratoire d’Analyses Médicales : Laboratoire d’Analyses Médicales
Publié le – Mis à jour le
Spécialité
Laboratoire
Contact
Service contact details
-
Secrétariat du service
Le laboratoire réalise des examens de biologie médicale pour toute personne, hospitalisée ou non.
Le détail des prestations est consultable en ligne : Notre Catalogue de Prestations
Pour tout examen de biologie médicale, il est nécessaire de se présenter au bureau des admissions à l’accueil principal de l’hôpital pour enregistrer votre venue .
Ouverture du lundi au vendredi de 7h à 17h30 avec ou sans rendez-vous
Une prise de rendez-vous est conseillée pour un traitement plus rapide de votre venue. Des conseils et des consignes à suivre vous seront délivrés selon votre prescription.
Prise de rendez-vous et venue à jeun obligatoires pour certains examens
En cas de doute n’hésitez pas à contacter le laboratoire ou consultez le Guide du laboratoire
Un formulaire dédié est à votre disposition à l’accueil du laboratoire pour nous faire part de vos remarques. Vous pouvez également nous écrire via le Guide du laboratoire